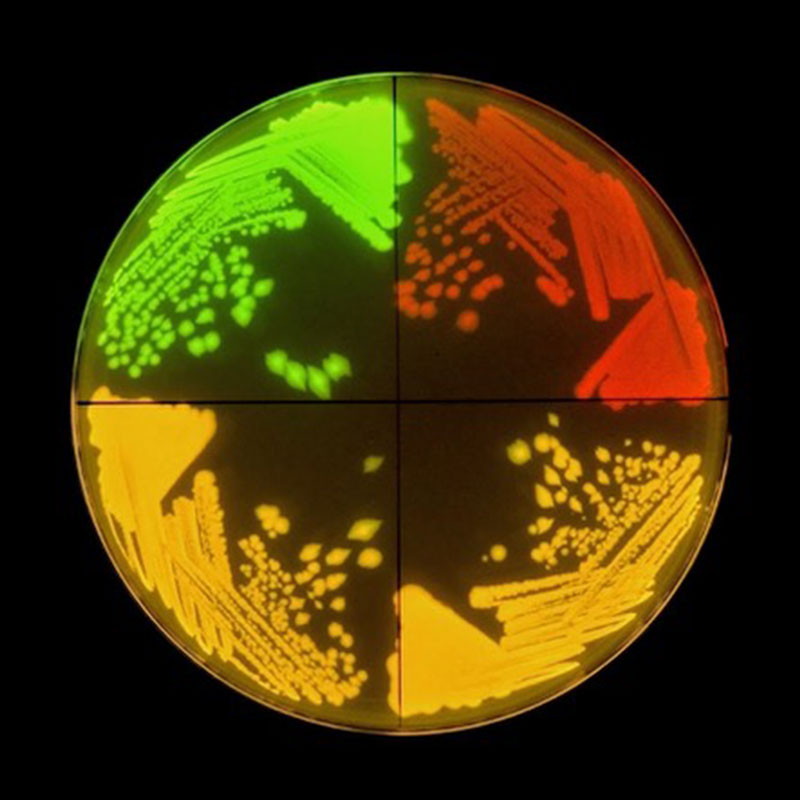
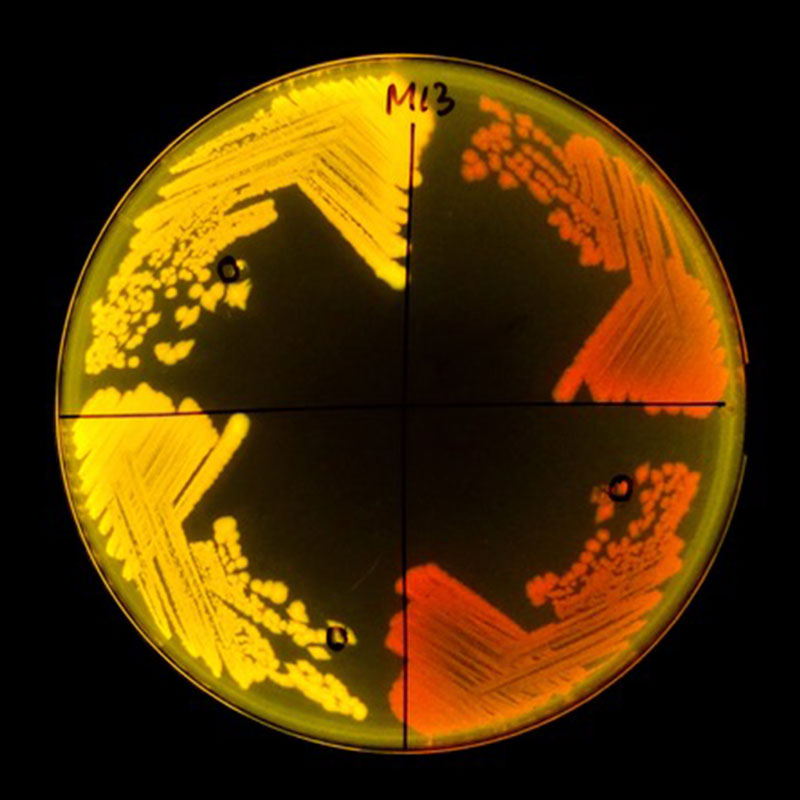

A child with asthma faces a lifetime of difficult symptoms from a condition that cannot be cured. But a new theory of the disease offers the hope it can be prevented by changing the microbial environment inside the child’s body.
With the help of a $70 million grant from the Audacious Project, an initiative of TED, a new collaboration is forming between researchers at UC San Francisco and UC Berkeley to edit the genes of microbes in the gut and airways that play a role in the disease. It is the first step toward what researchers hope will become a new branch of medicine centered on the microbiome.
UCSF’s Sue Lynch, PhD, who directs the Benioff Center for Microbiome Medicine (BCMM), will use CRISPR-based gene editing tools customized for the task by some of the world’s premier gene editing scientists at the Innovative Genomics Institute (IGI) – namely Nobel Laureate Jennifer Doudna, PhD, and microbiome specialist Jill Banfield, PhD, at UC Berkeley.
Their goal will be to perform precise edits to the genomes of microbial cells associated with asthma and move these modifications towards clinical trials in humans. What they learn will be applicable across the health spectrum.
The Audacious Project grant also contains an environmental component and supports work by IGI affiliate UC Davis to edit genes in the bovine microbiome that contribute to cows’ production of methane.
Until now, CRISPR gene editing has largely been used on cells cultured in the lab. The new initiative will take that technology into the body for the first time.
“We’re very excited about the possibility of developing a whole new realm of human therapeutics based on precision microbiome engineering,” said UCSF Chancellor Sam Hawgood, MBBS. “Asthma is a good starting point because we already have clear microbial targets to pursue.”
Delivering CRISPR
In 2019, Lynch, identified a small molecule produced by infant gut bacteria that predicts the risk of allergy and asthma in childhood. Since the microbes that make the molecule likely play other roles that are beneficial, eliminating them outright may not be the best approach. Instead, Lynch wants to edit their genomes to stop them from producing the molecule.
“We want to specifically remove the microbes’ capacity to produce this molecule while retaining its other functions,” Lynch said. “That way we can determine whether this alters the trajectory to asthma development.”
She also wants to leverage this technology to target respiratory pathogens that exacerbate asthma in the airways of older children.
The first stage of UCSF’s work will be devoted to identifying additional microbial genes linked to asthma through the first year of infant gut microbiome development, while UC Berkeley will be working in tandem to develop tools that can accurately deliver CRISPR machinery to those specific microbes in the baby’s digestive tract.
In 2021 Lynch’s colleague, Peter Turnbaugh, PhD, a professor of microbiology and immunology and a member of the BCMM, demonstrated it’s possible to use a virus to deliver gene-editing tools to E. coli in the gut microbiome of mice.
Plates of E. coli strains in the mouse gut, demonstrating Turnbaugh’s success editing a single gene:

Three separate E. coli strains that express green, red, and both (yellow).

Here, CRISPR gene editing machinery was delivered to the mouse’s gut using a virus, editing out the gene responsible for the green color.
Plates of E. coli strains in the mouse gut, demonstrating Turnbaugh’s success editing a single gene:
Three separate E. coli strains that express green, red, and both (yellow).
Here, CRISPR gene editing machinery was delivered to the mouse’s gut using a virus, editing out the gene responsible for the green color.
While sending CRISPR machinery to a well-understood bacterium in a mouse is no small feat, repeating the task in the human microbiome is far more complicated.
“It was Peter’s work that prompted us to consider applying CRISPR-based technology to precisely edit human microbiomes,” said Lynch, adding that there are well-established asthma-associated targets that her team will now aim to edit out of a person’s microbiome. “We believe this has potential as a novel approach to prevention and treatment of the disease.”
Before that’s possible, however, Lynch’s team will have to determine whether additional gene targets exist and work with Berkeley’s team to develop and refine delivery systems that can be tested in preclinical models and, ultimately, in clinical trials at UCSF.
Collaboration is Key
The Audacious project is designed specifically for this kind of collaboration, which Lynch said is central to integrating what have previously been separate fields, and it accelerates translation into the clinic.
“It’s a perfect marriage,” Lynch said. “We are taking improved gene editing tools and combining them with our understanding of how the microbiome promotes disease to develop novel microbiome interventions and test them in clinical trials.”
What they learn from applying these technologies to asthma-related microbes will aid in the study of the many other microbial environments in the body.
Lynch envisions a future in which patients will get microbiome screens to determine microbial traits that can safely be engineered in or out of the system through a suite of CRISPR-based tools.
“At UCSF, and particularly within the BCMM, we are focused on bringing these kinds of inter-disciplinary translational research efforts to bear on human health,” she said. “We want to leverage our rapidly developing knowledge of the human microbiome and tools such as CRISPR to build the next generation of precision therapeutics.”
